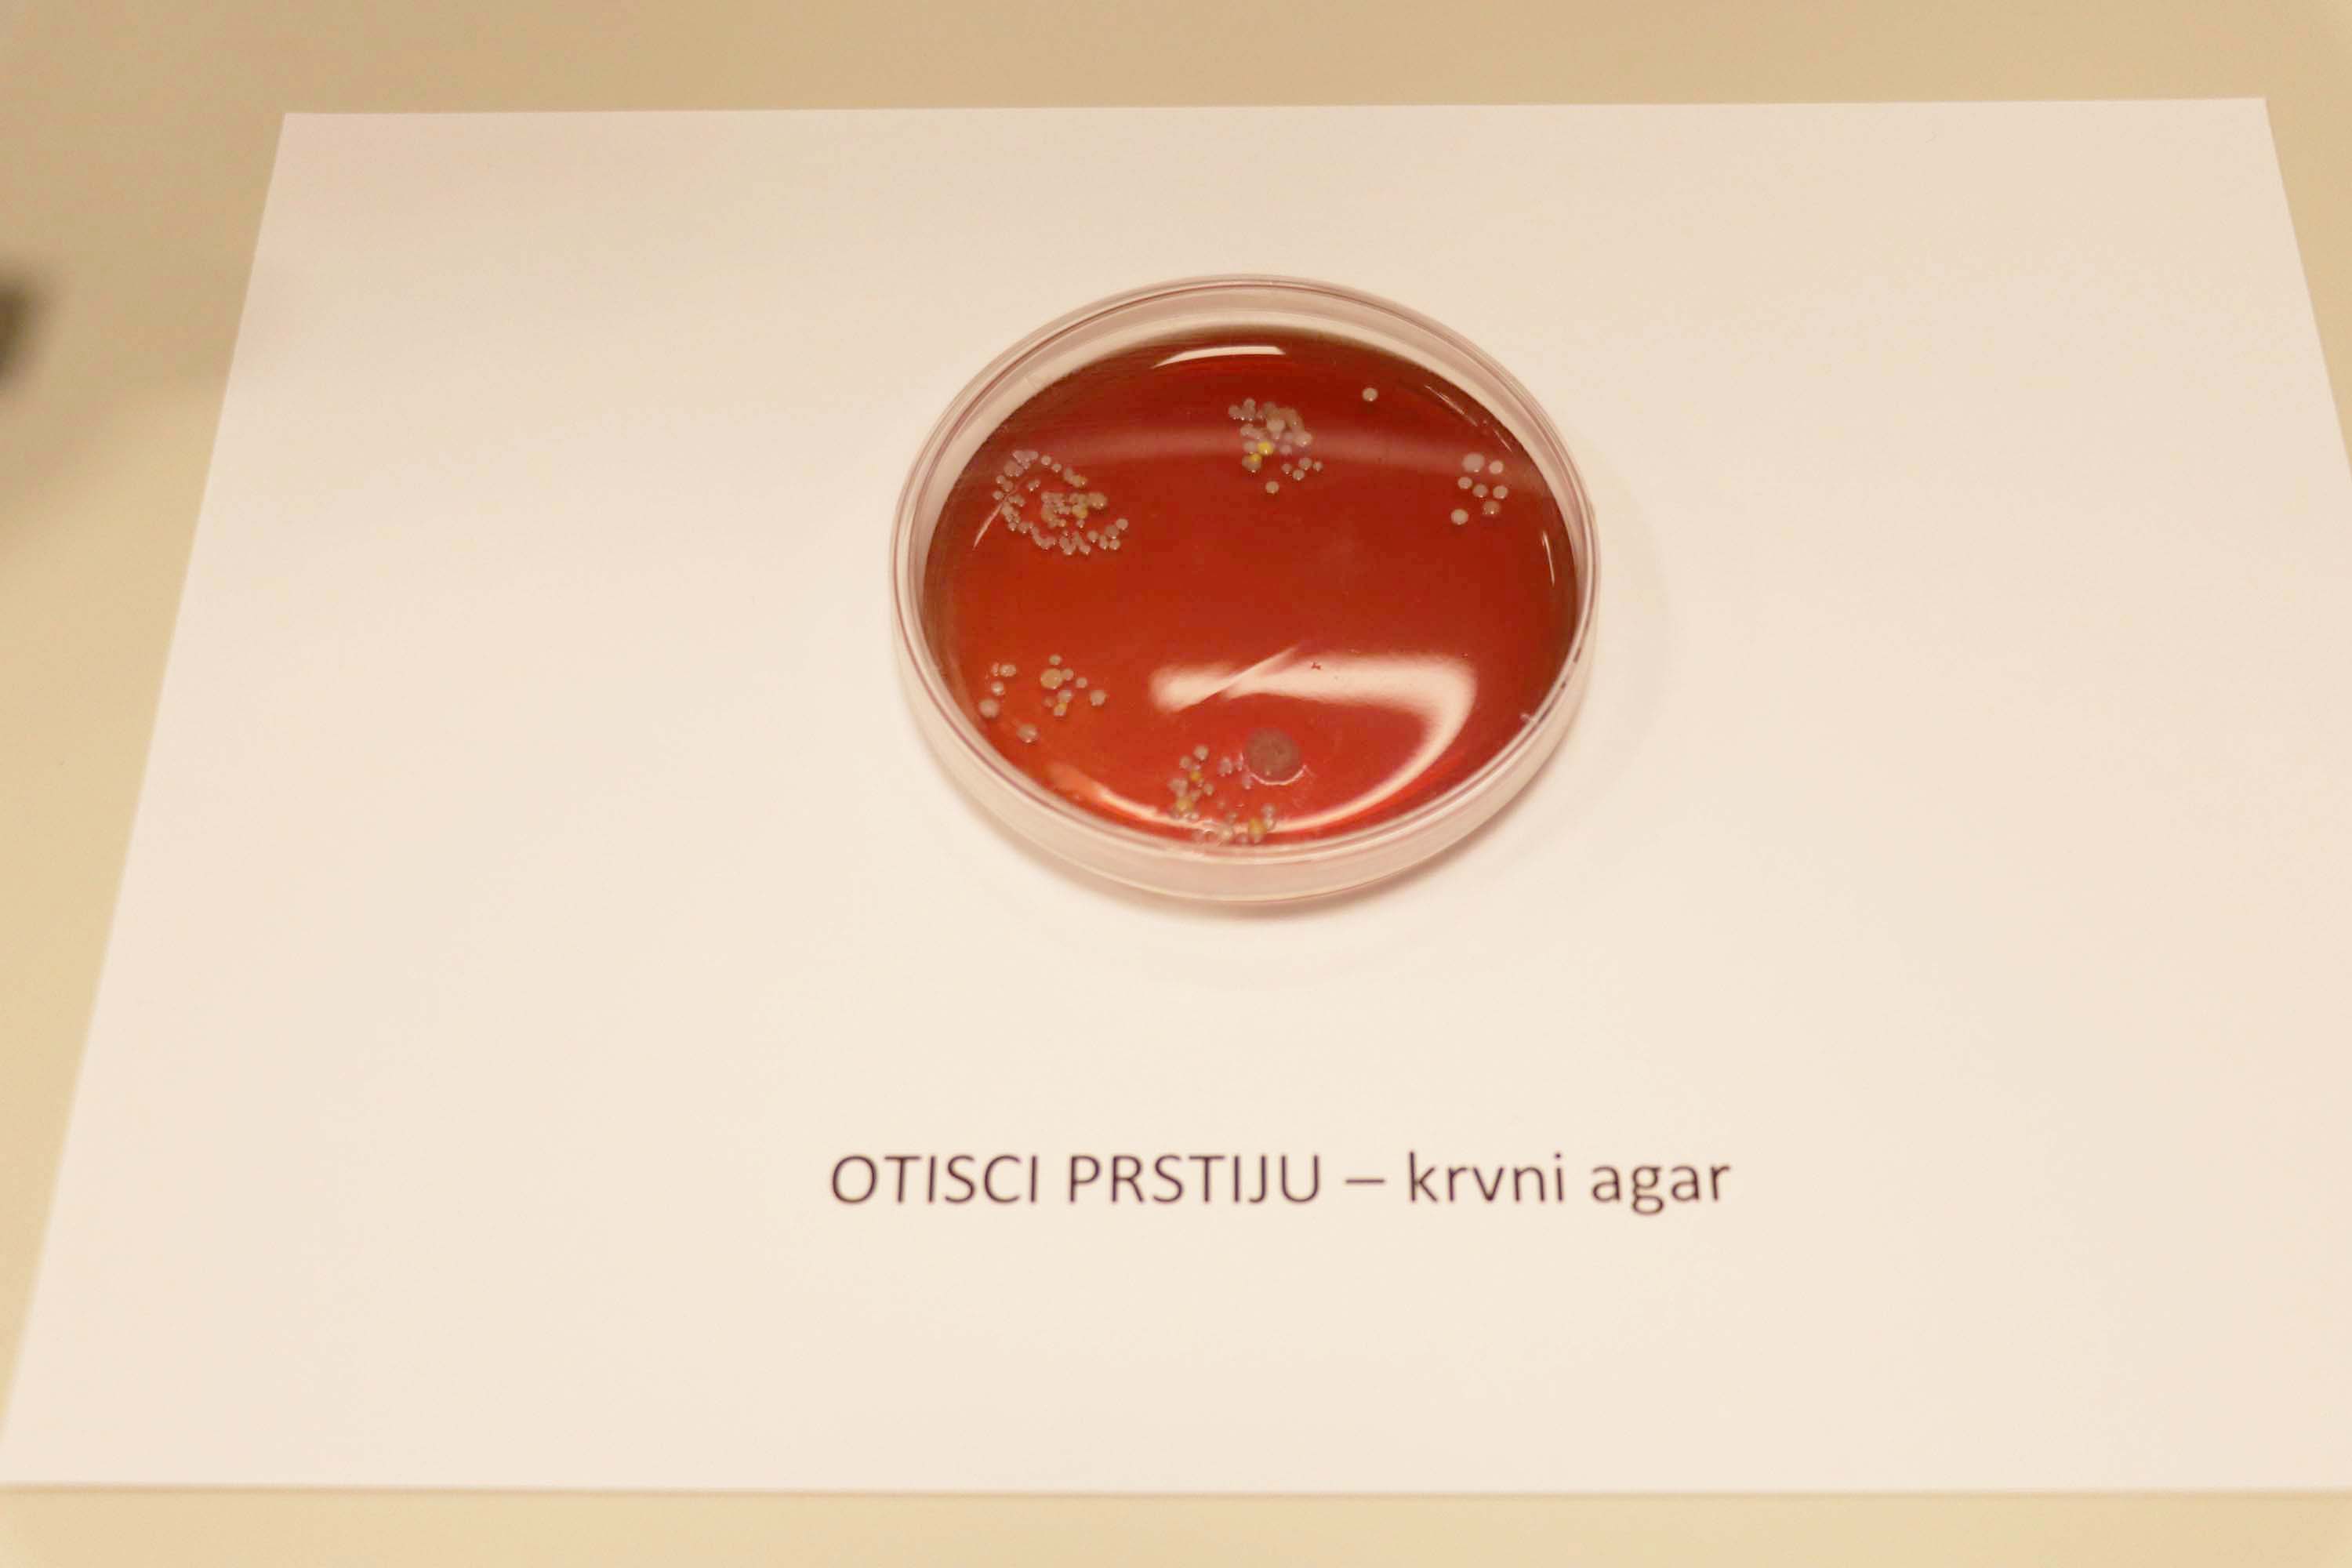
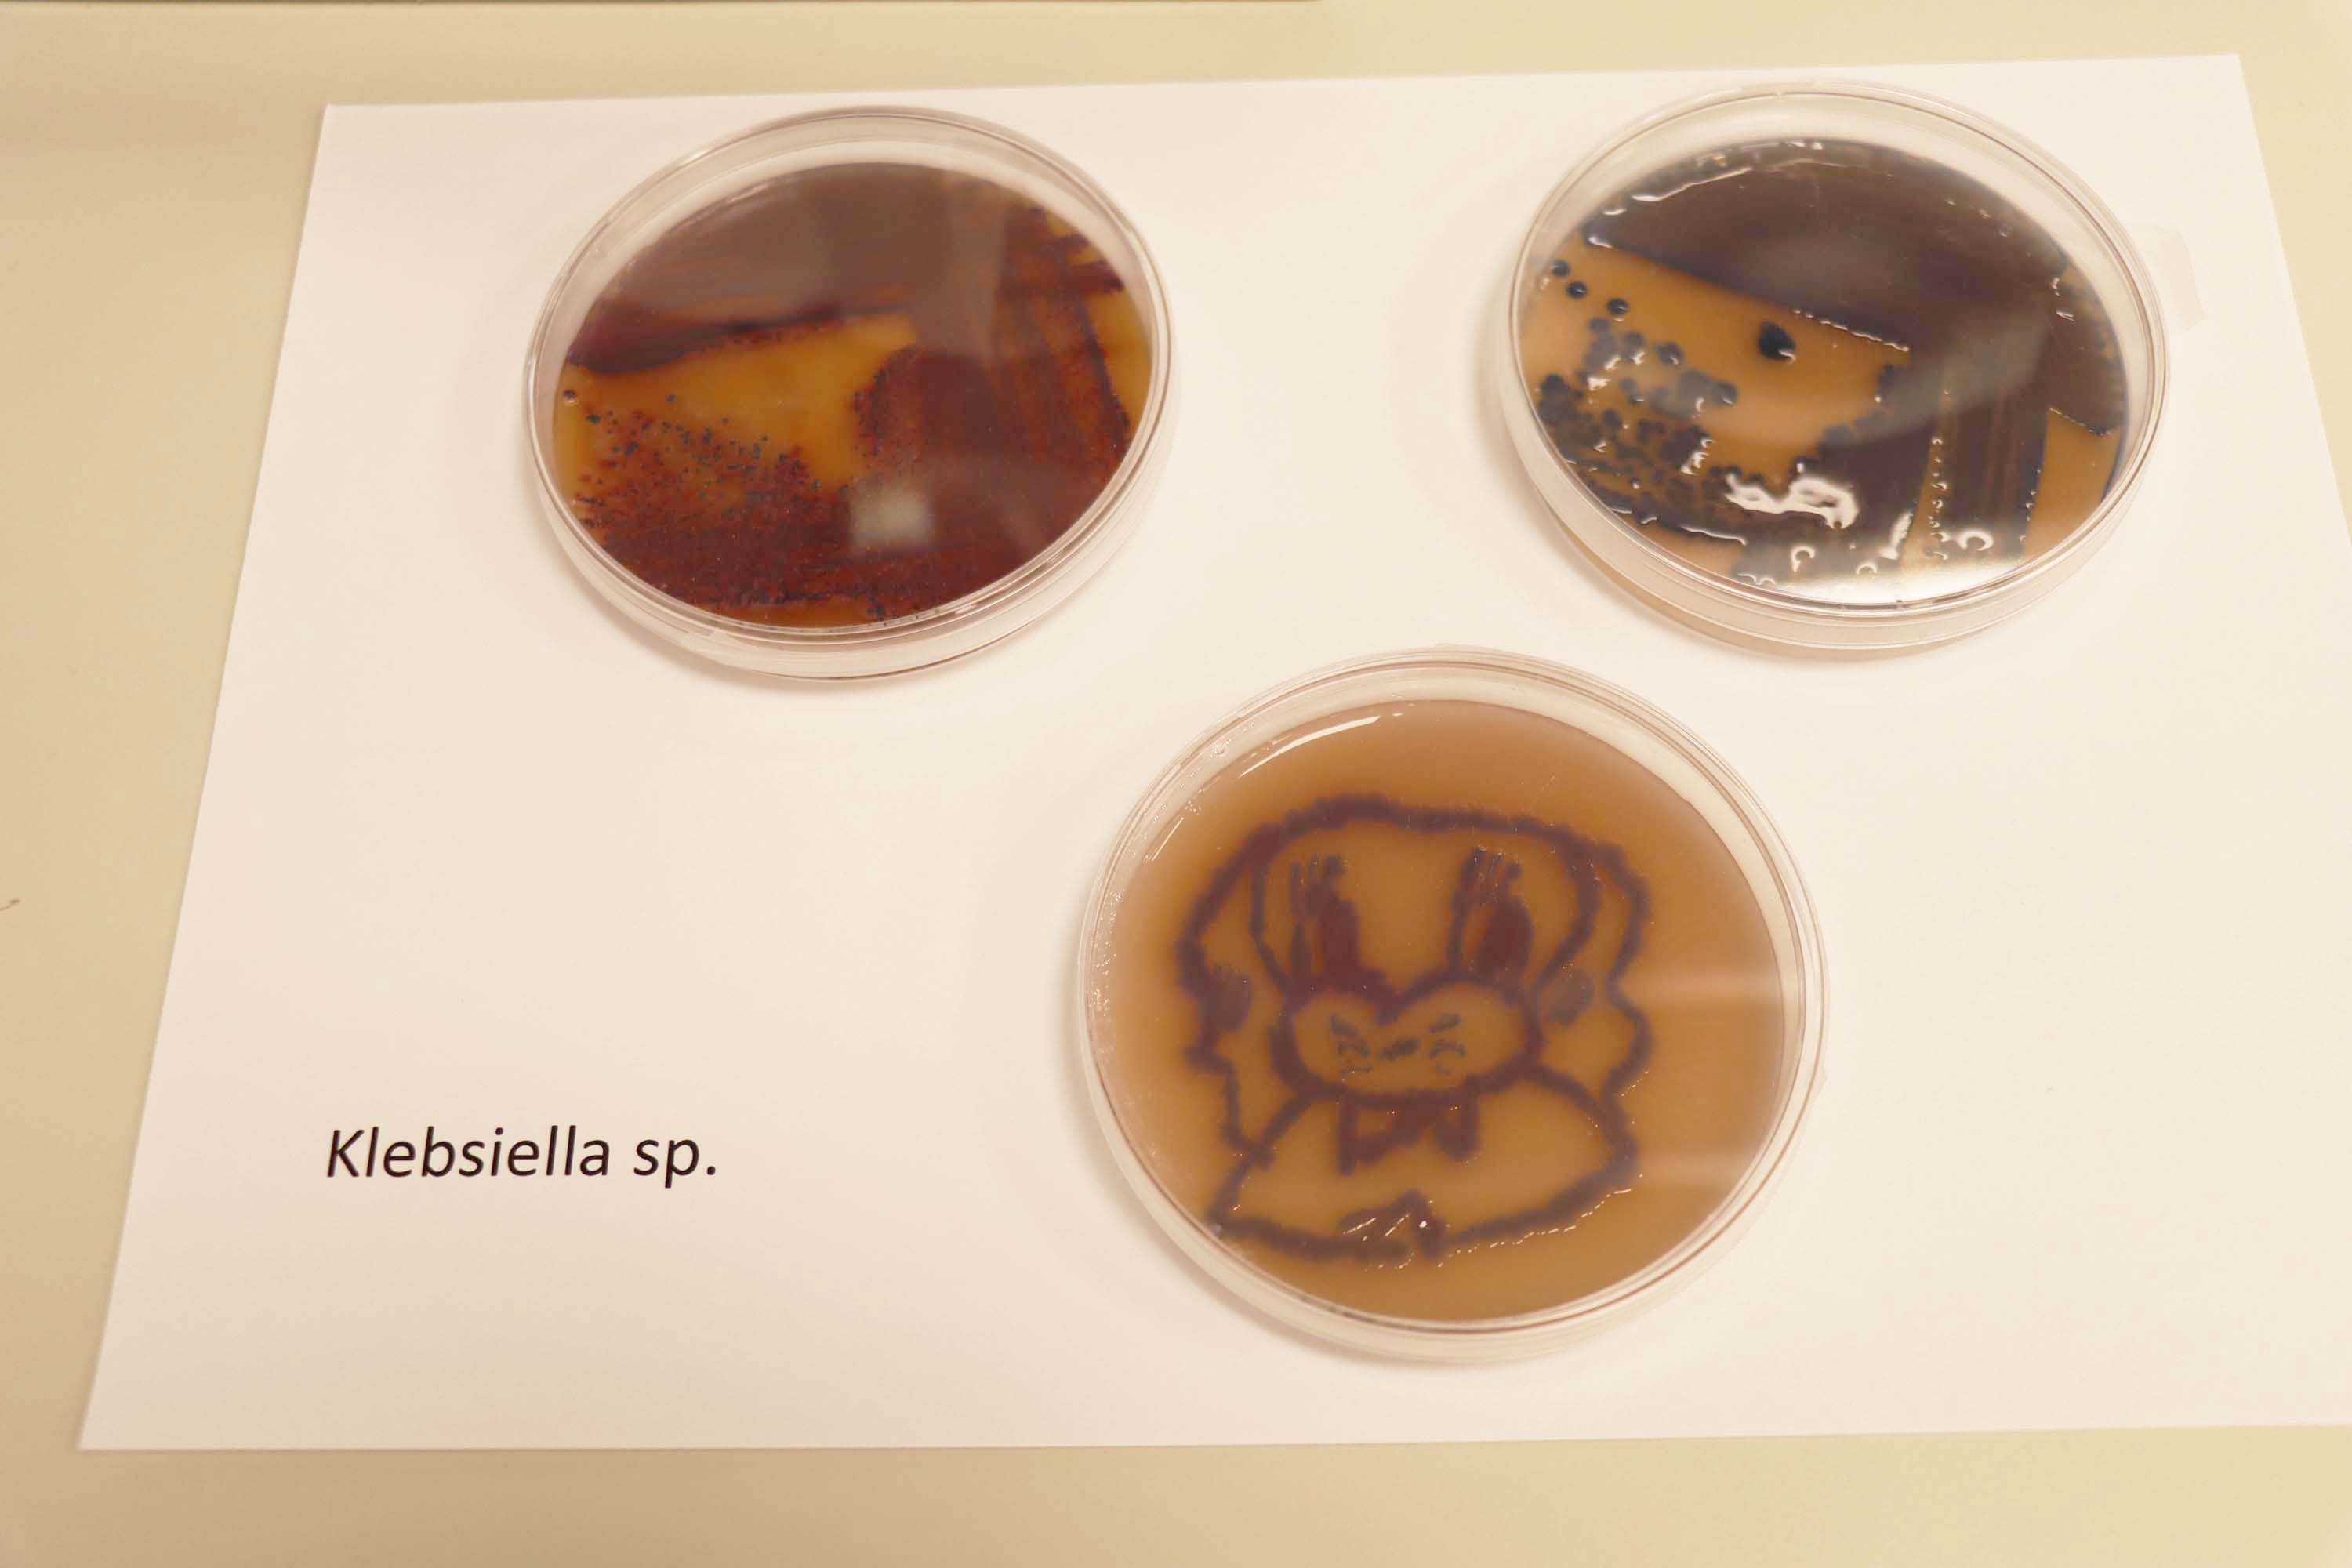
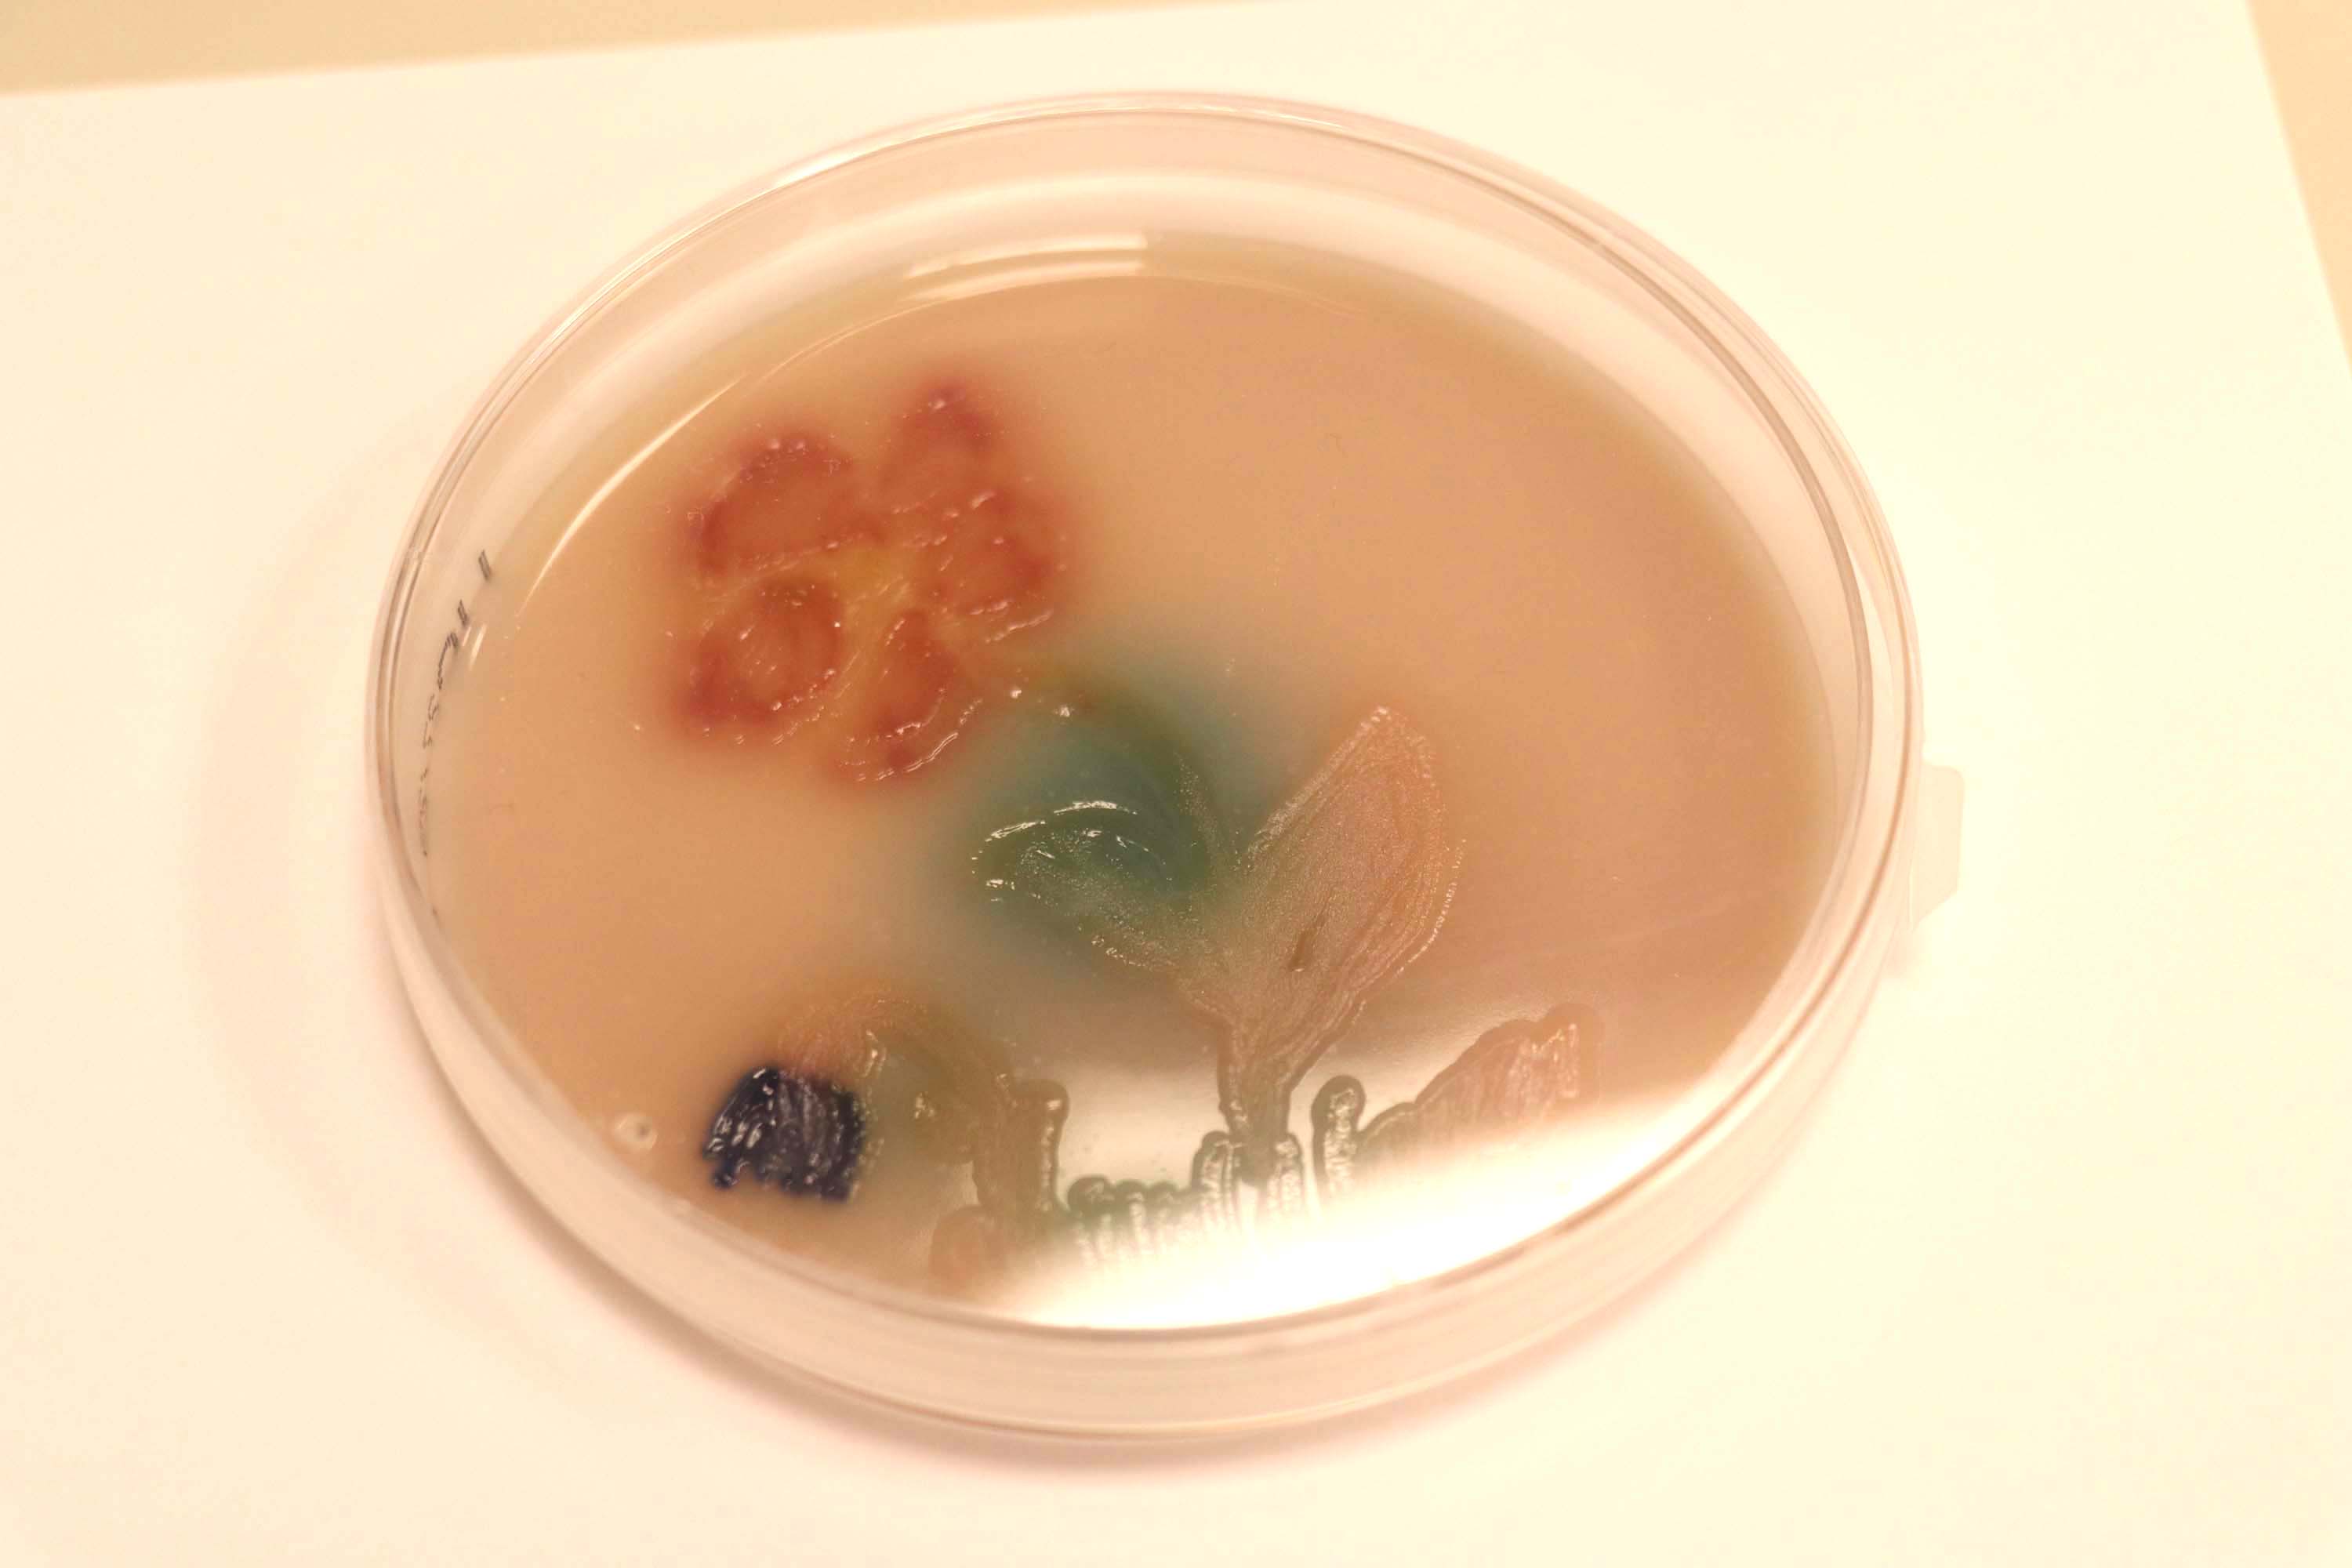

Share
Održan info dan Medicinskog fakulteta HKS-a
U utorak 27. svibnja 2025. Medicinski fakultet Hrvatskoga katoličkog sveučilišta otvorio je svoja vrata maturanticama i maturantima koji konkuriraju za upise u sljedećoj akademskoj godini.

Uvodnu riječ ispred Sveučilišta i Fakulteta održao je dekan MEF-a prof. dr. sc. Dalibor Karlović.

Program studija i način studiranja medicine na HKS-u predstavili su nastavnici doc. dr. sc. Momir Futo i doc. dr. sc. Tihana Magdić Turković, a o svojem iskustvu studiranja medicine na HKS-u govorili su studentica prve godine medicine Nejla Bektić i student treće godine medicine Matija Lasović.

Posjetitelji su potom obišli prostore u kojima se održava praktična nastava, gdje su imali prilike vidjeti demonstracije vježbi iz kemije, biokemije, biologije, mikrobiologije, mikroskopiranja preparata zdravih i bolesnih tkiva, stjecanja vještina na modelima za učenje liječničkog umijeća te isprobati rad na stolu za učenje anatomije – Anatomage-u.

Polaznici su izrazili svoje oduševljenje ovim posjetom i zahvalili nastavnicima i studentima koji su im pokazali kako studij medicine na HKS-u traži mnogo rada i odricanja od studenata, ali također mnogo i daje – od samog programa koji studentima pruža korisno znanje koje vrlo brzo mogu primijeniti u kliničkoj praksi pa do iskustva zajedništva i suradnje s kolegama i nastavnicima zbog kojih uloženi napori rezultiraju boljim rezultatima i većim zadovoljstvom studiranja. Poseban pečat ovom događaju dali su studenti medicine koji su svoja iskustva studiranja svojim budućim kolegama prenosili s toliko žara i oduševljenja da su polaznici na kraju zaključili da sada HKS svakako postaje njihov prvi izbor.